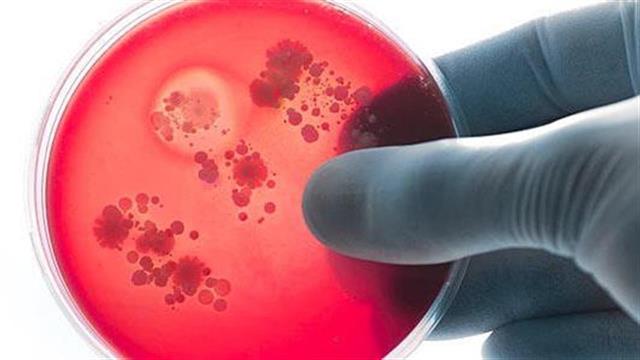
Μαθήματα ζωής από το 6χρονο κοριτσάκι στο Καματερό που νόσησε από μηνιγγίτιδα Β και ακρωτηριάστηκε

Τον Οκτώβριο του 2016, το 5χρονο τότε κοριτσάκι εμφάνισε υψηλό πυρετό, πονοκέφαλο και συνεχείς εμετούς, ενώ μέσα σε 12 ώρες το σώμα του γέμισε εξανθήματα. Άμεσα μεταφέρθηκε σε ιδιωτική κλινική και από εκεί στο Αγλαΐα Κυριακού, όπου οι γιατροί διέγνωσαν μηνιγγίτιδα τύπου Β. Η μηνιγγίτιδα εξελίχθηκε ραγδαία και το κοριτσάκι νοσηλεύτηκε στην Μονάδα Εντατικής Θεραπείας για μια εβδομάδα παλεύοντας για την ίδια του τη ζωή!
Παρόλο που το μικρό κορίτσι κατάφερε να νικήσει τη μηνιγγίτιδα, η μηνιγγίτιδα είχε ήδη προκαλέσει σηψαιμία και εκτεταμένες νεκρώσεις στην περιοχή της φτέρνας και των δαχτύλων, με αποτέλεσμα οι θεράποντες ιατροί να προχωρήσουν σε πολλαπλές χειρουργικές επεμβάσεις
Μετά από 7 μήνες συνεχούς μάχης και παρατεταμένης νοσηλείας, παρόλες τις προσπάθειες των γιατρών, κρίθηκε απαραίτητος ο ακρωτηριασμός του ποδιού του 6χρονου κοριτσιού από το γόνατο και κάτω, και η χρήση πρόσθετου μέλους.
Σήμερα, μετά από αυτή την συγκλονιστική περιπέτεια και την προσπάθεια τόσο του ίδιου του παιδιού, των θεραπόντων ιατρών, όσο και της οικογένειας, το κοριτσάκι είναι υγιές και συνεχίζει κανονικά τη ζωή του, αποτελώντας παράδειγμα ψυχικού σθένους και αποφασιστικότητας αφού κατάφερε να νικήσει μια τόσο σοβαρή ασθένεια που μπορεί να προκαλέσει ακόμα και θάνατο.
Το συγκεκριμένο περιστατικό και η πορεία της υγείας του παιδιού, καταδεικνύει τη σημασία της σωστής ενημέρωσης των γονέων για τα συμπτώματα της νόσου και της έγκαιρης πρόληψης μέσω του εμβολιασμού.
Προσθέστε το iatronet.gr στο DiscoverΕιδήσεις υγείας σήμερα
Οικογένεια: Το κρίσιμο μέτρο που έχει μείνει στο...ράφι
Mέσος όρος 69% το νοσοκομειακό clawback
Φάρμακο: Καθυστερήσεις και εμπόδια στην πρόσβαση των ασθενών
ΑΠΘ: Σε σταθερή και βελτιούμενη κατάσταση ο φοιτητής με μηνιγγίτιδα
ΑΠΘ: Σε σταθερή και βελτιούμενη κατάσταση ο φοιτητής με μηνιγγίτιδα Αναστάτωση από κρούσμα μηνιγγίτιδας στην Κτηνιατρική Σχολή του ΑΠΘ
Αναστάτωση από κρούσμα μηνιγγίτιδας στην Κτηνιατρική Σχολή του ΑΠΘ Η μηνιγγίτιδα παραμένει απειλή: Συνδέεται με χιλιάδες θανάτους παγκοσμίως
Η μηνιγγίτιδα παραμένει απειλή: Συνδέεται με χιλιάδες θανάτους παγκοσμίως ECDC: Πόσο κινδυνεύουν οι Ευρωπαίοι από την έξαρση μηνιγγίτιδας στο Ηνωμένο Βασίλειο
ECDC: Πόσο κινδυνεύουν οι Ευρωπαίοι από την έξαρση μηνιγγίτιδας στο Ηνωμένο Βασίλειο Συναγερμός στην Αγγλία λόγω έξαρσης μηνιγγίτιδας
Συναγερμός στην Αγγλία λόγω έξαρσης μηνιγγίτιδας ΕΜΑ: Κίνδυνος άσηπτης μηνιγγίτιδας από το εμβόλιο κατά του ιού τσικουνγκούνια
ΕΜΑ: Κίνδυνος άσηπτης μηνιγγίτιδας από το εμβόλιο κατά του ιού τσικουνγκούνια Οικογένεια: Το κρίσιμο μέτρο που έχει μείνει στο...ράφι
Οικογένεια: Το κρίσιμο μέτρο που έχει μείνει στο...ράφι Φάρμακο: Καθυστερήσεις και εμπόδια στην πρόσβαση των ασθενών
Φάρμακο: Καθυστερήσεις και εμπόδια στην πρόσβαση των ασθενών "Το γάλα της λήθης": Έγκριση νέου αναισθητικού στις ΗΠΑ
"Το γάλα της λήθης": Έγκριση νέου αναισθητικού στις ΗΠΑ Μπορούν τρόφιμα να ενισχύσουν την απορρόφηση της βιταμίνης D;
Μπορούν τρόφιμα να ενισχύσουν την απορρόφηση της βιταμίνης D; Ρύζι, πατάτες και ζυμαρικά: Ποιο είναι χειρότερο για το σάκχαρο;
Ρύζι, πατάτες και ζυμαρικά: Ποιο είναι χειρότερο για το σάκχαρο; Με ποιες τροφές να συνδυάζω ρύζι, πατάτες και ζυμαρικά για να μην αυξάνεται απότομα το σάκχαρο
Με ποιες τροφές να συνδυάζω ρύζι, πατάτες και ζυμαρικά για να μην αυξάνεται απότομα το σάκχαρο Pharmathen: Βαθιά κρίση και μηδενισμός αποτίμησης από funds της Partners
Pharmathen: Βαθιά κρίση και μηδενισμός αποτίμησης από funds της Partners Καρπούζι: Ποια είναι τα οφέλη του στην υγεία
Καρπούζι: Ποια είναι τα οφέλη του στην υγεία Ιατρικός Σύλλογος Θεσσαλονίκης: Σαρωτική επικράτηση της ΕΝΟ.ΣΥ. - Ν.Ι.Κ.Ι.
Ιατρικός Σύλλογος Θεσσαλονίκης: Σαρωτική επικράτηση της ΕΝΟ.ΣΥ. - Ν.Ι.Κ.Ι. Φαρμακοβιομηχανίες σκέφτονται να χτυπήσουν την πόρτα της Εθνικής Αρχής Διαφάνειας
Φαρμακοβιομηχανίες σκέφτονται να χτυπήσουν την πόρτα της Εθνικής Αρχής Διαφάνειας Οι απρόσμενες συνέπειες της ολοκληρωτικής παράλειψης της ζάχαρης από τη διατροφή [μελέτη]
Οι απρόσμενες συνέπειες της ολοκληρωτικής παράλειψης της ζάχαρης από τη διατροφή [μελέτη] 9 εξακριβωμένα οφέλη του κολοκυθόσπορου
9 εξακριβωμένα οφέλη του κολοκυθόσπορου